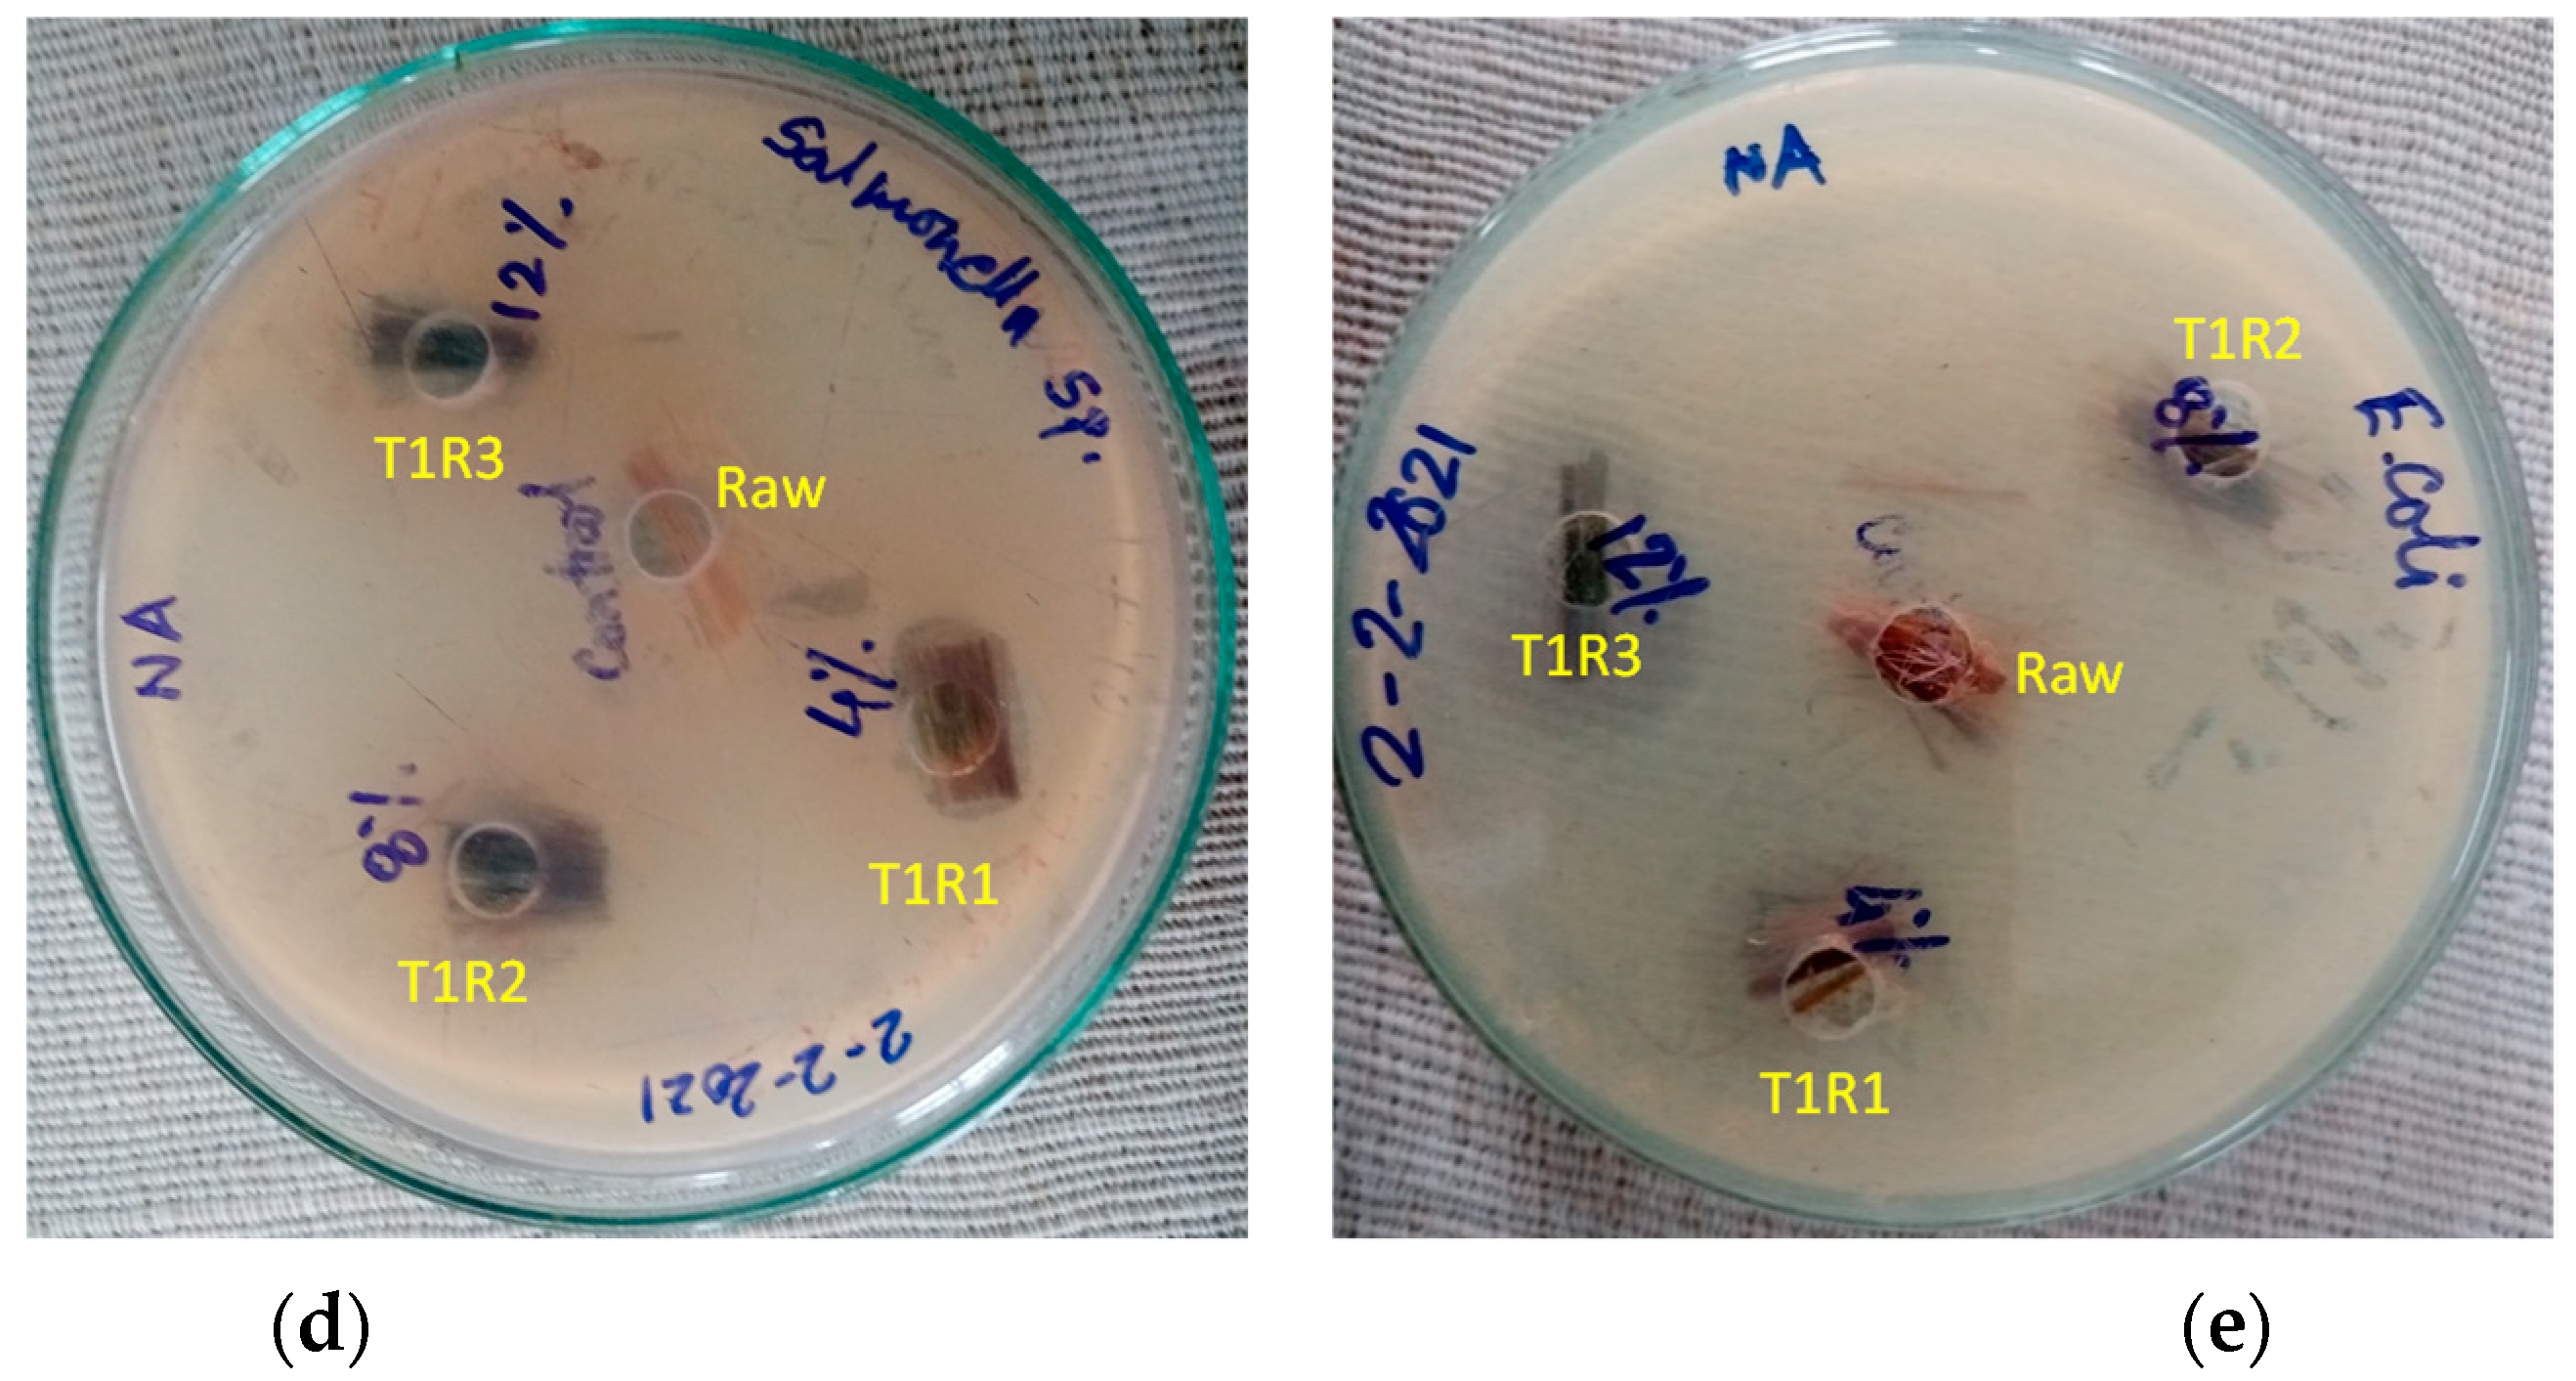

Effect of Rot-, Fire-, and Water-Retardant Treatments on Jute Fiber and Their Associated Thermoplastic Composites: A Study by FTIR
Abstract
:1. Introduction
2. Materials and Methods
2.1. Fiber Collection and Treatment
2.2. Evaluation of Chemical Treatments
2.2.1. Anti-Bacterial Test
2.2.2. Flammability Test
2.2.3. Contact Angle Test
2.3. FTIR Characterization of Fiber
2.4. Composite Fabrication and Characterization
3. Results and Discussions
3.1. Rot-, Fire-, and Water-Retardant Fiber Characteristics
3.2. FTIR Analysis of the Jute Fibers
3.2.1. Microstructural Characteristics of Untreated Jute Fiber
3.2.2. FTIR Spectra Analysis of Rot-Retardant Jute Fiber
3.2.3. FTIR Spectra Analysis of Fire-Retardant Jute Fiber
3.2.4. FTIR Spectra Analysis of Water-Retardant Jute Fiber
3.3. FTIR Analysis of the Jute Fiber-Reinforced Composite
3.4. Results Summary
4. Conclusions
Author Contributions
Funding
Data Availability Statement
Acknowledgments
Conflicts of Interest
References
- Salem, T.F.; Tirkes, S.; Akar, A.O.; Tayfun, U. Enhancement of mechanical, thermal and water uptake performance of TPU/jute fiber green composites via chemical treatments on fiber surface. e-Polymers 2020, 20, 133–143. [Google Scholar] [CrossRef] [Green Version]
- Khan, M.; Hinrichsen, G.; Drzal, L. Influence of novel coupling agents on mechanical properties of jute reinforced polypropylene composite. J. Mater. Sci. Lett. 2018, 20, 1711–1713. [Google Scholar] [CrossRef]
- Baykus, O.; Mutlu, A.; Doğan, M. The effect of pre-impregnation with maleated coupling agents on mechanical and water absorption properties of jute fabric reinforced polypropylene and polyethylene biocomposites. J. Compos. Mater. 2016, 50, 257–267. [Google Scholar] [CrossRef]
- Shahinur, S.; Hasan, M.; Ahsan, Q.; Jafrin, S. Effect of Rot-Retardant Treatment on Properties of Jute Fibers. J. Nat. Fibers 2016, 14, 205–216. [Google Scholar] [CrossRef]
- Biswas, S.; Shahinur, S.; Hasan, M.; Ahsan, Q. Physical, Mechanical and Thermal Properties of Jute and Bamboo Fiber Reinforced Unidirectional Epoxy Composites. Procedia Eng. 2015, 105, 933–939. [Google Scholar] [CrossRef] [Green Version]
- Sayeed, M.M.A.; Sayem, A.S.; Haider, J. Opportunities with Renewable Jute Fiber Composites to Reduce Eco-Impact of Non-renewable Polymers. In Encyclopedia of Renewable and Sustainable Materials; Hashmi, S., Choudhury, I.A., Eds.; Elsevier: Oxford, UK, 2020; pp. 810–821. [Google Scholar]
- Chubuike, E.O.M.; Ebele, C.C.; Ifeanyi, E.I.F.; Okwuc, E.S. January study on chemical treatments of jute fiber for application in natural fiber reinforced composites (NFRPC). Int. J. Adv. Eng. Res. Sci. 2017, 4, 21–26. [Google Scholar] [CrossRef]
- Jafrin, S.; Shahinur, S.; Khayer, M.; Dilruba, A.; Assaduzzaman, M.; Dhali, S. Effect of weak acid and weak alkali on jute fibre and fabrics in physical properties. Indian J. Nat. Fiber 2014, 1, 83–90. [Google Scholar]
- Anwer, M.M.; Hossen, M.Z.; Akhter, S.; Morshed, N.; Talukder, P.; Alam, A.; Islam, M.A. Direct current electrical properties of plasma treated jute. Int. J. Eng. Appl. Sci. 2019, 6, 11–14. [Google Scholar]
- Islam, J.M.; Hossan, M.A.; Alom, F.; Khan, M.I.H.; Khan, M.A. Extraction and characterization of crystalline cellulose from jute fiber and application as reinforcement in biocomposite: Effect of gamma radiation. J. Compos. Mater. 2017, 51, 31–38. [Google Scholar] [CrossRef]
- Kahar, P. Synergistic effects of pretreatment process on enzymatic digestion of rice straw for efficient ethanol fermentation. In Environmental Biotechnology-New Approaches and Prospective Applications; Petre, M., Ed.; Intech Open: London, UK, 2013; pp. 65–87. [Google Scholar]
- Ali, Z.; Gao, Y.; Tang, B.; Wu, X.; Wang, Y.; Li, M.; Hou, X.; Li, L.; Jiang, N.; Yu, J. Preparation, Properties and Mechanisms of Carbon Fiber/Polymer Composites for Thermal Management Applications. Polymers 2021, 13, 169. [Google Scholar] [CrossRef]
- Sarkar, A.M.; Nayeem, J.; Popy, R.S.; Quadery, A.H.; Jahan, M.S. Dissolving pulp from jute wastes. Bioresour. Technol. Rep. 2018, 4, 96–100. [Google Scholar] [CrossRef]
- Shahinur, S.; Hasan, M. Jute/Coir/Banana Fiber Reinforced Bio-Composites: Critical Review of Design, Fabrication, Properties and Applications. In Encyclopedia of Renewable and Sustainable Materials; Hashmi, S., Choudhury, I.A., Eds.; Elsevier: Oxford, UK, 2020; pp. 751–756. [Google Scholar]
- Kishore, M.; Amrita, M.; Kamesh, B. Experimental investigation of milling on basalt-jute hybrid composites with graphene as nanofiller. Mater. Today Proc. 2021, 43, 726–730. [Google Scholar] [CrossRef]
- Joshua, O.I.; Comfort, A.A.; Samuel, O.; Adewale, G.A.; Sulyman, A.A. An empirical review of the recent advances in treatment of natural fibers for reinforced plastic composites. Compos. Interfaces 2020, 1–36. [Google Scholar] [CrossRef]
- Fernandes, I.P.; Barbosa, M.; Amaral, J.; Pinto, V.; Rodrigues, J.L.; Ferreira, M.J.; Barreiro, M.F. Biobased Additives as Biodegradability Enhancers with Application in TPU-Based Footwear Components. J. Renew. Mater. 2016, 4, 47–56. [Google Scholar] [CrossRef]
- Hossen, J.; Begum, H.A.; Uddin, M.; Islam, M.T.; Islam, M. Investigating the Physical Properties of Treated and Untreated Jute Fibre-Polyester Composites. Asian J. Text. 2018, 8, 13–21. [Google Scholar] [CrossRef]
- Shahinur, S.; Hasan, M.; Ahsan, Q.; Haider, J. Effect of Chemical Treatment on Thermal Properties of Jute Fiber Used in Polymer Composites. J. Compos. Sci. 2020, 4, 132. [Google Scholar] [CrossRef]
- Ilyas, R.; Sapuan, S.; Asyraf, M.; Dayana, D.; Amelia, J.; Rani, M.; Norrrahim, M.; Nurazzi, N.; Aisyah, H.; Sharma, S.; et al. Polymer Composites Filled with Metal Derivatives: A Review of Flame Retardants. Polymers 2021, 13, 1701. [Google Scholar] [CrossRef]
- Kanbur, Y.; Tayfun, U. Development of multifunctional polyurethane elastomer composites containing fullerene: Mechanical, damping, thermal, and flammability behaviors. J. Elastomers Plast. 2019, 51, 262–279. [Google Scholar] [CrossRef]
- Ueda, Y.; Sakai, Y.; Oke, T.; Iguchi, M. Microscope observation of a droplet surface on a plate by coating of a water-repellent material. J. Vis. 2010, 13, 179–180. [Google Scholar] [CrossRef]
- Klaber, J.H. Composition for waterproofing and fireproofing textile material, and the treated material. U.S. Patent 2,424,831, 29 July 1947. [Google Scholar]
- Hospodarova, V.; Singovszka, E.; Stevulova, N. Characterization of cellulosic fibers by FTIR spectroscopy for their further imple-mentation to building materials. Am. J. Anal. Chem. 2018, 9, 303–310. [Google Scholar] [CrossRef] [Green Version]
- Atykyan, N.; Revin, V.; Shutova, V. Raman and FT-IR Spectroscopy investigation the cellulose structural differences from bacteria Gluconacetobacter sucrofermentans during the different regimes of cultivation on a molasses media. AMB Express 2020, 10, 84. [Google Scholar] [CrossRef] [PubMed]
- Garside, P.; Wyeth, P. Identification of Cellulosic Fibres by FTIR Spectroscopy-Thread and Single Fibre Analysis by Attenuated Total Reflectance. Stud. Conserv. 2003, 48, 269–275. [Google Scholar] [CrossRef] [Green Version]
- Nandiyanto, A.; Oktiani, R.; Ragadhita, R. How to read and interpret FTIR spectroscope of organic materia. Indones. J. Sci. Technol. 2019, 4, 97–118. [Google Scholar] [CrossRef]
- Zhou, G.; Taylor, G.; Polle, A. FTIR-ATR-based prediction and modelling of lignin and energy contents reveals independent intra-specific variation of these traits in bioenergy poplars. Plant Methods 2011, 7, 9. [Google Scholar] [CrossRef] [Green Version]
- De Castro, B.D.; Silva, K.M.M.N.; Maziero, R.; De Faria, P.E.; Silva-Caldeira, P.P.; Rubio, J.C.C. Influence of Gamma Radiation Treatment on the Mechanical Properties of Sisal Fibers to Use into Composite Materials. Fibers Polym. 2020, 21, 1816–1823. [Google Scholar] [CrossRef]
- Maria, P.; Pantani, R. Determination of crystallinity of an aliphatic polyester by FTIR spectroscopy. Polym. Bull. 2007, 59, 403–412. [Google Scholar]
- Kann, Y.; Shurgalin, M.; Krishnaswamy, R. FTIR spectroscopy for analysis of crystallinity of poly(3-hydroxybutyrate-co-4 -hydroxybutyrate) polymers and its utilization in evaluation of aging, orientation and composition. Polym. Test. 2014, 40, 218–224. [Google Scholar] [CrossRef]
- Jafrin, S.; Dilruba, F.A.; Haider, M.K. Studies on the Suitable Rot-Proof Processes for Manufacturing More Sustainable Jute Based Nursery Pot. Int. J. Eng. Appl. Sci. 2018, 5, 257197. [Google Scholar]
- Khatton, A.; Hossen, M.; Sultana, N.; Ahsan, M.L. Effect of Di-ammonium Hydrogen Phosphate on Jute Fabric for Fire Resistance. Sci. J. Energy Eng. 2019, 7, 63–66. [Google Scholar] [CrossRef]
- Asagekar, S.D. Study of Performance Characteristics of Fabrics Coated with PVC based Formulations. J. Text. Sci. Eng. 2016, 6, 237. [Google Scholar] [CrossRef] [Green Version]
- Jorgensen, J.; Turnidge, J. Susceptibility test methods: Dilution and disk diffusion methods. In Manual of Clinical Microbiology; Jorgensen, J., Carroll, K.C., Funke, G., Pfaller, M.A., Landry, M.L., Richter, S.S., Warnock, D.W., Eds.; Wiley: Washington, DC,, USA, 2015. [Google Scholar]
- Aranci, K.; Uzun, M.; Su, S.; Cesur, S.; Ulag, S.; Amin, A.; Guncu, M.M.; Aksu, B.; Kolayli, S.; Ustundag, C.B.; et al. 3D Propolis-Sodium Alginate Scaffolds: Influence on Structural Parameters, Release Mechanisms, Cell Cytotoxicity and Antibacterial Activity. Molecules 2020, 25, 5082. [Google Scholar] [CrossRef]
- Wayne, P. Clinical and Laboratory Standards Institute (CLSI). In Performance Standards for Antimicrobial Susceptibility Testing, 27th ed.; Clinical and Laboratory Standards Institute: Wayne, PA, USA, 2010. [Google Scholar]
- Staff, C. Laboratory Test Manual for 16 CFR Part 1610: Standard for the Flammability of Clothing Textiles; United States Consumer Product Safety Commission: Bethesda, MD, USA, 2008. [Google Scholar]
- Pietak, A.; Korte, S.; Tan, E.; Downard, A.; Staiger, M.P. Atomic force microscopy characterization of the surface wettability of natural fibers. Appl. Surf. Sci. 2007, 253, 3627–3635. [Google Scholar] [CrossRef]
- Parvin, F.; Jannat, S.; Tareq, S.M. Abundance, characteristics and variation of microplastics in different freshwater fish species from Bangladesh. Sci. Total Environ. 2021, 784, 147137. [Google Scholar] [CrossRef]
- Bhuiyan, M.A.R.; Islam, A.; Islam, S.; Hossain, A.; Nahar, K. Improving dyeability and antibacterial activity of Lawsonia inermis L on jute fabrics by chitosan pretreatment. Text. Cloth. Sustain. 2017, 3, 1–10. [Google Scholar] [CrossRef] [Green Version]
- Chaitanya, S.; Cheedarala, R.K.; Song, J.I. Microwave-synthesized Mg+ 2 doped jute fibers and their application as a reinforcement in biocomposites. Compos. Part B Eng. 2020, 197, 108154. [Google Scholar] [CrossRef]
- Basak, S.; Samanta, K.K.; Chattopadhyay, S.K.; Das, S.; Narkar, R.; Dsouza, C.; Shaikh, A.H. Flame retardant and antimicrobial jute textile using sodium metasilicate nonahydrate. Pol. J. Chem. Technol. 2014, 16, 106–113. [Google Scholar] [CrossRef] [Green Version]
- Demirci, N.; Demirel, M.; Dilsiz, N. Surface Modification of PVC Film with Allylamine Plasma Polymers. Adv. Polym. Technol. 2014, 33. [Google Scholar] [CrossRef]
- Ammayappan, L.; Chakraborty, S.; Pan, N.C. Silica nanocomposite based hydrophobic functionality on jute textiles. J. Text. Inst. 2021, 112, 470–481. [Google Scholar] [CrossRef]
- Dayan, A.R.; Habib, M.; Kaysar, M.A.; Uddin, M. Study on the Physico-Mechanical Properties of Okra Fibre at Different Harvesting Time. Saudi J. Eng. Technol. 2020, 5, 304–309. [Google Scholar] [CrossRef]
- Bodîrlău, R.; Teacă, C.A. Fourier transform infrared spectroscopy and thermal analysis of lignocellulose fillers treated with organic anhydrides. Rom. J. Phys. 2009, 54, 93–104. [Google Scholar]
- Roy, K.; Debnath, S.C.; Tzounis, L.; Pongwisuthiruchte, A.; Potiyaraj, P. Effect of Various Surface Treatments on the Performance of Jute Fibers Filled Natural Rubber (NR) Composites. Polymers 2020, 12, 369. [Google Scholar] [CrossRef] [PubMed] [Green Version]
- Fuzhi, S.; Qihua, W.; Tingmei, W. The effects of crystallinity on the mechanical properties and the limiting PV (pres-sure×velocity) value of PTFE. Tribol. Int. 2016, 93 Pt A, 1–10. [Google Scholar]
- Shahinur, S.; Hasan, M.; Ahsan, Q. Outcome of rot retardant treatment on the mechanical properties of different portion jute fiber. Bangladesh J. Phys. 2013, 13, 59–64. [Google Scholar]
- Acemioglu, B.; Hakki, M. Equilibrium studies on adsorption of Cu(ii) from aqueous solution onto cellulose. J. Colloid Interface Sci. 2001, 243, 81–84. [Google Scholar] [CrossRef]
- Busigny, V.; Cartigny, P.; Philippot, P.; Javoy, M. Ammonium quantification in muscovite by infrared spectroscopy. Chem. Geol. 2003, 198, 21–31. [Google Scholar] [CrossRef]
- Sharma, Y. Elementary Organic Spectroscopy; S. Chand & Company Ltd.: New Delhi, India, 2000. [Google Scholar]
- Sayem, A.S.M.; Haider, J.; Naveed, B.; Sayeed, M.M.A.; Sashikumar, S. Thermoplastic Composites reinforced with Multi-layer Woven Jute Fabric: A Comparative Analysis. Adv. Mater. Process. Technol. 2020, 1–25. [Google Scholar] [CrossRef]
- Shahinur, S.; Ahsan, Q.; Hasan, M.; Jafrin, S. Characterization of CuSO4 (rot proof) treated jute fiber. In Proceedings of the 3rd International Conference on Structure, Processing and Properties of Materials (SPPM 2010), Dhaka, Bangladesh, 24–26 February 2010. [Google Scholar]
- Aldajah, S.; Al-Haik, M.Y.; Siddique, W.; Kabir, M.M.; Haik, Y. Mechanical and thermal characterization of grafted PP-NCC nanocomposites. J. Thermoplast. Compos. Mater. 2019, 1–14. [Google Scholar] [CrossRef]
- Brahim, S.B.; Cheikh, R.B. Influence of fiber orientation and volume fraction on the tensile properties of unidirectional Alfa-polyester composite. Compos. Sci. Technol. 2007, 67, 140–147. [Google Scholar] [CrossRef]

| Sample Code | Name of Treatment | Chemical Name | Physical Form | Molecular Weight (gm/mol) | Chemical Concentration (wt.%) | Sample Colour | Composite | |
|---|---|---|---|---|---|---|---|---|
| T0 | - | - | - | ![]() Light golden | J-PP | |||
| T1 | T1R1 | Rot retardant | CuSO4·5H2O | Blue granule | 249.68 | 4 | ![]() Light bluish | JT1-PP |
| T1R2 | 8 | |||||||
| T1R3 | 12 | |||||||
| T2 | T2F1 | Fire retardant | (NH4)2·HPO4 | White granule | 132.06 | 20 | ![]() Bright golden | JT2-PP |
| T2F2 | 25 | |||||||
| T2F3 | 30 | |||||||
| T3 | T3W1 | Water retardant | ([C2H3Cl]n or PVC | White powder | 48,000 | 10 | ![]() Bright brown | JT3-PP |
| T3W2 | 15 | |||||||
| T3W3 | 20 | |||||||
| Bacteria/Strain | T1R1 | T1R2 | T1R3 |
|---|---|---|---|
| Acinetobacter sp. | 14.5 ± 0.6 | 14.4 ± 0.2 | 19.9 ± 0.4 |
| Pseudomonas sp. | 15.2 ± 0.48 | 19.3 ± 0.04 | 24.6 ± 0.28 |
| Salmonella sp. | 0 | 0 | 0 |
| E. coli | 0 | 0 | 12.2 ± 0.42 |
| Bacillus cereus | 17.8 ± 0.06 | 20.7 ± 0.02 | 20.9 ± 0.05 |
| Band Position (cm–1) | Functional Group | Ref. |
|---|---|---|
| ~3600–3200 | ν(OH) broad, strong bond from the cellulose, hemicelluloses, and lignin of jute | [46,48] |
| ~3000–2900 | ν(C–H) in aromatic ring and alkenes | |
| ~2930–2910 | C–H methyl and methylene groups | |
| ~1740–1730 | C= O carbonyls | |
| ~1750–1710 | ν(C=O) most probably from the lignin and hemicelluloses | |
| ~1650–1630 | Possibly aromatic ring | |
| ~1640–1618 | C=C alkenes | |
| ~1630–1642.6 | Probably absorb water | |
| ~1515–1504 | ν(C=C) aromatic in plane | |
| ~1501–1510 | ν(C=C) aromatic skeletal ring vibration due to lignin | |
| ~1462–1425 | CH2 cellulose, lignin | |
| ~1460–1468 | δ (C–H: C–OH) 1o and 2o alcohol | |
| ~1422–1428 | δ (C–H) | |
| ~1384–1346 | C–H cellulose, hemicelluloses | |
| ~1365–1377 | δ(C–H) | |
| ~1315 | δ(C–H) | |
| ~1280 | δ(C–H2) twisting | |
| ~1260–1234 | O–H phenolic | |
| ~1170–1153 | O–H alcohols (primary and secondary) and aliphatic ethers | |
| ~1155 | ν(C–C) ring breathing, asymmetric | |
| ~1112 | ν(C–O–C) glycosidic | |
| ~1055 | ν(C–O–C) 2o alcohol | |
| ~1033 | ν(C–O–C) 1o alcohol | |
| ~910 | C=C alkenes | |
| ~895 | ν(C–O–C) in plane, symmetric |
| Wavelength (cm−1) | Peak Details | Reference | |
|---|---|---|---|
| 3600–3200 | O-H | [27] | |
| 1700–1750 | Lignin and hemicellulose | [46] | |
| 1500–1100 | Lignin fingerprint | [50] | |
| 1130–1080/680–610 5 | Sulphate ion (SO4) | [27] | |
| 1380–1350/840–815 5 | Sulfur | ||
| 1050 1300–1350 1380–1400 | Sulfate group Sulfoxide Sulfone/Sulfuric acid | SO4 | [Spectra Base™, Wiley. https://spectrabase.com/ accessed on 25 July 2021] |
| Wavelength (cm−1) | Peak Details | Reference |
|---|---|---|
| 3620–3630 | OH | [52] |
| 3300–3030/1430–13905 | Ammonium ion | [27] |
| 2800 to 3400 | N–H stretching | |
| 2350 | N–H | |
| 1730 to 2150 | O–H stretching | |
| 1430 | N–H bending | |
| 1100–1000 | Phosphate ion | |
| 1050–990 | Aliphatic phosphate (P–O–C stretch) | |
| 400 | Aliphatic iodo compounds C-I | |
| 500 |
| Wavelength (cm−1) | Peak Details | Reference | |
|---|---|---|---|
| 1420–1410 | Vinyl C–H in plane bend Vinyl C–H out of plane bend | Functional group | [27] |
| 995–985/915–890 | |||
| 1300–800 | Esterification | ||
| 1000 | Vinyl-related compound | ||
| 800–700 | Aliphatic chloro compound, C–Cl stretch | ||
| Treated Jute Fiber Features | Rot-Retardant Fiber (T1) | Fire-Retardant Fiber (T2) | Water-Retardant Fiber (T3) |
|---|---|---|---|
| Cellulosic and hemicellulose OH | Present and shifted right | Present and shifted right | Present |
| Characteristic peak | SO4 | NH, PO4 | Cl, vinyl |
| Crystallinity | Increased with chemical concentration | Increased with chemical concentration | Increased with chemical concentration |
| Change in level of retardant characteristics | Present and increased with chemical concentration | Present and increased with chemical concentration | Present and increased with chemical concentration |
| Possible evidences of retardant characteristics | Increasing inhibition zone with chemical concentration | Decreasing burning area | Decreasing contact angle |
Publisher’s Note: MDPI stays neutral with regard to jurisdictional claims in published maps and institutional affiliations. |
© 2021 by the authors. Licensee MDPI, Basel, Switzerland. This article is an open access article distributed under the terms and conditions of the Creative Commons Attribution (CC BY) license (https://creativecommons.org/licenses/by/4.0/).
Share and Cite
Shahinur, S.; Hasan, M.; Ahsan, Q.; Sultana, N.; Ahmed, Z.; Haider, J. Effect of Rot-, Fire-, and Water-Retardant Treatments on Jute Fiber and Their Associated Thermoplastic Composites: A Study by FTIR. Polymers 2021, 13, 2571. https://doi.org/10.3390/polym13152571
Shahinur S, Hasan M, Ahsan Q, Sultana N, Ahmed Z, Haider J. Effect of Rot-, Fire-, and Water-Retardant Treatments on Jute Fiber and Their Associated Thermoplastic Composites: A Study by FTIR. Polymers. 2021; 13(15):2571. https://doi.org/10.3390/polym13152571
Chicago/Turabian StyleShahinur, Sweety, Mahbub Hasan, Qumrul Ahsan, Nayer Sultana, Zakaria Ahmed, and Julfikar Haider. 2021. "Effect of Rot-, Fire-, and Water-Retardant Treatments on Jute Fiber and Their Associated Thermoplastic Composites: A Study by FTIR" Polymers 13, no. 15: 2571. https://doi.org/10.3390/polym13152571
APA StyleShahinur, S., Hasan, M., Ahsan, Q., Sultana, N., Ahmed, Z., & Haider, J. (2021). Effect of Rot-, Fire-, and Water-Retardant Treatments on Jute Fiber and Their Associated Thermoplastic Composites: A Study by FTIR. Polymers, 13(15), 2571. https://doi.org/10.3390/polym13152571





